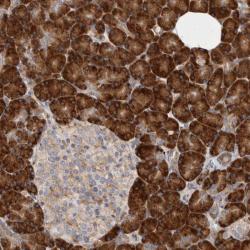

Antibody data
- Antibody Data
- Antigen structure
- References [3]
- Comments [0]
- Validations
- Western blot [1]
- Immunohistochemistry [1]
Submit
Validation data
Reference
Comment
Report error
- Product number
- sc-17754 - Provider product page

- Provider
- Santa Cruz Biotechnology
- Proper citation
- Santa Cruz Biotechnology Cat#sc-17754, RRID:AB_2247471
- Product name
- Anti-GNB2L1
- Antibody type
- Monoclonal
- Antigen
- Recombinant full-length protein
- Reactivity
- Human
- Host
- Mouse
Submitted references Keratin 8/18 modulation of protein kinase C-mediated integrin-dependent adhesion and migration of liver epithelial cells.
High-throughput identification of IMCD proteins using LC-MS/MS.
Combined proteomics and pathways analysis of collecting duct reveals a protein regulatory network activated in vasopressin escape.
Bordeleau F, Galarneau L, Gilbert S, Loranger A, Marceau N
Molecular biology of the cell 2010 May 15;21(10):1698-713
Molecular biology of the cell 2010 May 15;21(10):1698-713
High-throughput identification of IMCD proteins using LC-MS/MS.
Pisitkun T, Bieniek J, Tchapyjnikov D, Wang G, Wu WW, Shen RF, Knepper MA
Physiological genomics 2006 Apr 13;25(2):263-76
Physiological genomics 2006 Apr 13;25(2):263-76
Combined proteomics and pathways analysis of collecting duct reveals a protein regulatory network activated in vasopressin escape.
Hoorn EJ, Hoffert JD, Knepper MA
Journal of the American Society of Nephrology : JASN 2005 Oct;16(10):2852-63
Journal of the American Society of Nephrology : JASN 2005 Oct;16(10):2852-63
No comments: Submit comment
Supportive validation
- Submitted by
- per
- Main image

- Experimental details
- Western blot analysis of antibody specificity using a routine panel composed of IgG/HSA-depleted human plasma and protein lysates from selected human tissues and cell lines.
- Validation comment
- Single band corresponding to the predicted size in kDa (+/-20%).
- Primary Ab dilution
- 1:500
- Secondary Ab dilution
- 1:7000
- Lane 1
- Marker [kDa]: 230, 110, 82, 49.3, 32.2, 25.5, 17.6
- Lane 2
- RT-4
- Lane 3
- U-251MG sp
- Lane 4
- Human Plasma
- Lane 5
- Liver
- Lane 6
- Tonsil
- Theoretical target weight
- [kDa] 38
Supportive validation
- Submitted by
- per
- Main image
- Experimental details
- Immunohistochemical staining of human pancreas shows strong positivity in exocrine cells.
- Validation comment
- Staining pattern partly consistent with experimental and/or bioinformatic data.